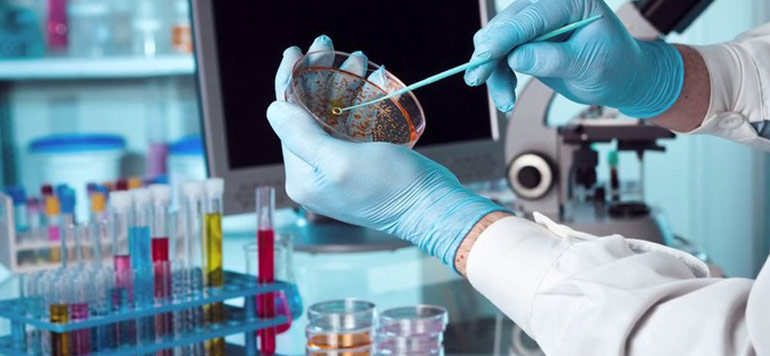
tab 01

Elite Mold Inspections, Inc. is a State of Florida licensed assessment and remediation company
Elite Mold Inspections provides high quality mold related inspections and testing of residential and commercial properties. Our mission is to provide the highest quality service to our community, focusing on taking care of our clients, and providing prompt, professional services
PROVIDING FIRST CLASS SERVICES.
Services we Provide


WHAT WE DO
We offer free inspections, unfortunately air sample tests if you need them are not. Testing keeps everyone informed. Testing isn’t expensive, but it does give you peace of mind, and stops you from worrying. If you have a mold problem air tests give us a scientific map of what’s going on. Different molds represent different types of leaks, and how long you home has been wet. Our independent lab studies these samples and gives us quick accurate results. By comparing the outside air with that of the inside, we can determine if you have more than just a surface mold problem. Testing after we are done the remediation is essential as it gives you and I confidence your home is safe again. We can discuss your report, and decide what the best options are.
We also specialize in
Water Damage & Removal
Mold Damage & Removal
Fire & Smoke Damage
Disaster Damage
Flood & Storm Damage


WHAT WE DO
We offer free inspections, unfortunately air sample tests if you need them are not. Testing keeps everyone informed. Testing isn’t expensive, but it does give you peace of mind, and stops you from worrying. If you have a mold problem air tests give us a scientific map of what’s going on. Different molds represent different types of leaks, and how long you home has been wet. Our independent lab studies these samples and gives us quick accurate results. By comparing the outside air with that of the inside, we can determine if you have more than just a surface mold problem. Testing after we are done the remediation is essential as it gives you and I confidence your home is safe again. We can discuss your report, and decide what the best options are.
We also specialize in
Water Damage & Removal
Mold Damage & Removal
Fire & Smoke Damage
Disaster Damage
Flood & Storm Damage


WHAT WE DO
We offer free inspections, unfortunately air sample tests if you need them are not. Testing keeps everyone informed. Testing isn’t expensive, but it does give you peace of mind, and stops you from worrying. If you have a mold problem air tests give us a scientific map of what’s going on. Different molds represent different types of leaks, and how long you home has been wet. Our independent lab studies these samples and gives us quick accurate results. By comparing the outside air with that of the inside, we can determine if you have more than just a surface mold problem. Testing after we are done the remediation is essential as it gives you and I confidence your home is safe again. We can discuss your report, and decide what the best options are.
We also specialize in
Water Damage & Removal
Mold Damage & Removal
Fire & Smoke Damage
Disaster Damage
Flood & Storm Damage

WHAT WE DO
We offer free inspections, unfortunately air sample tests if you need them are not. Testing keeps everyone informed. Testing isn’t expensive, but it does give you peace of mind, and stops you from worrying. If you have a mold problem air tests give us a scientific map of what’s going on. Different molds represent different types of leaks, and how long you home has been wet. Our independent lab studies these samples and gives us quick accurate results. By comparing the outside air with that of the inside, we can determine if you have more than just a surface mold problem. Testing after we are done the remediation is essential as it gives you and I confidence your home is safe again. We can discuss your report, and decide what the best options are.
We also specialize in
Water Damage & Removal
Mold Damage & Removal
Fire & Smoke Damage
Disaster Damage
Flood & Storm Damage


WHAT WE DO
We offer free inspections, unfortunately air sample tests if you need them are not. Testing keeps everyone informed. Testing isn’t expensive, but it does give you peace of mind, and stops you from worrying. If you have a mold problem air tests give us a scientific map of what’s going on. Different molds represent different types of leaks, and how long you home has been wet. Our independent lab studies these samples and gives us quick accurate results. By comparing the outside air with that of the inside, we can determine if you have more than just a surface mold problem. Testing after we are done the remediation is essential as it gives you and I confidence your home is safe again. We can discuss your report, and decide what the best options are.
We also specialize in
Water Damage & Removal
Mold Damage & Removal
Fire & Smoke Damage
Disaster Damage
Flood & Storm Damage

Water Damage
Water can be one of the most damaging substances to any property and that’s why you need a reliable 24 hour water extraction service that you can count on.

Fire Damage
We understand how different materials react to fire, heat and smoke and what steps to take to minimize the damage, clean and repair your property and contents.

Mold Remediation
We can help you maintain a clean and healthy lifestyle as mold is not only a terrible eyesore, but also a dangerous health risk. Our team can diagnose any problem.



